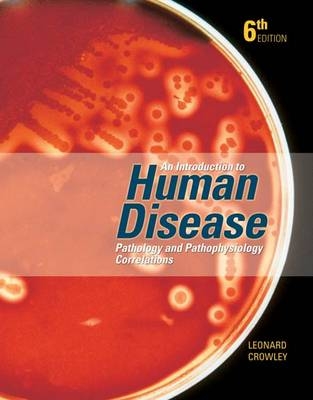
An Introduction to Human Disease - Leonard Crowley

An Introduction to Human Disease
Jones and Bartlett Publishers, Inc
978-0-7637-2966-0 (ISBN)
- Titel erscheint in neuer Auflage
- Artikel merken
Dr. Leonard Crowley was an experienced physician and educator based in the Minnesota twin cities of Minneapolis and St. Paul. He had a broad background in both the practice of medicine and the education of nursing students and undergraduate students in allied health professions, as well as medical students and graduate students in health related professions. Dr. Crowley received a M.Sc. degree from Ohio State University and an M.D. degree from the University of Vermont College of Medicine. Following graduation he received additional training at Columbia University College of Physicians and Surgeons and Presbyterian Hospital in New York, and at Ohio State University in Columbus Ohio. He held faculty appointments in the Department of Laboratory Medicine and Pathology at the University of Vermont and Ohio State University, and in the Department of Family Practice and Community Health and in the Department of Laboratory Medicine and Pathology at the University of Minnesota.' He was also an Honorary Medical Staff Physician at the University of Minnesota Medical Center, Fairview.' His most recent faculty appointment was in the Biology Department at Century College where he was actively involved in teaching undergraduate students in various health-related subjects, including his very popular course dealing with human disease pathophysiology,' pathology, clinical manifestations, and principles of treatment.Dr. Crowley's interest in undergraduate teaching dates back to his early experience teaching nursing students at Columbia Presbyterian Medical Center in New York when he was a resident physician in the Department of Pathology. He combined his interest in undergraduate teaching with his medical practice throughout his professional career.
| Erscheint lt. Verlag | 8.9.2004 |
|---|---|
| Verlagsort | Sudbury |
| Sprache | englisch |
| Gewicht | 2665 g |
| Themenwelt | Studium ► 1. Studienabschnitt (Vorklinik) ► Physiologie |
| Studium ► 2. Studienabschnitt (Klinik) ► Pathologie | |
| ISBN-10 | 0-7637-2966-3 / 0763729663 |
| ISBN-13 | 978-0-7637-2966-0 / 9780763729660 |
| Zustand | Neuware |
| Informationen gemäß Produktsicherheitsverordnung (GPSR) | |
| Haben Sie eine Frage zum Produkt? |
aus dem Bereich


